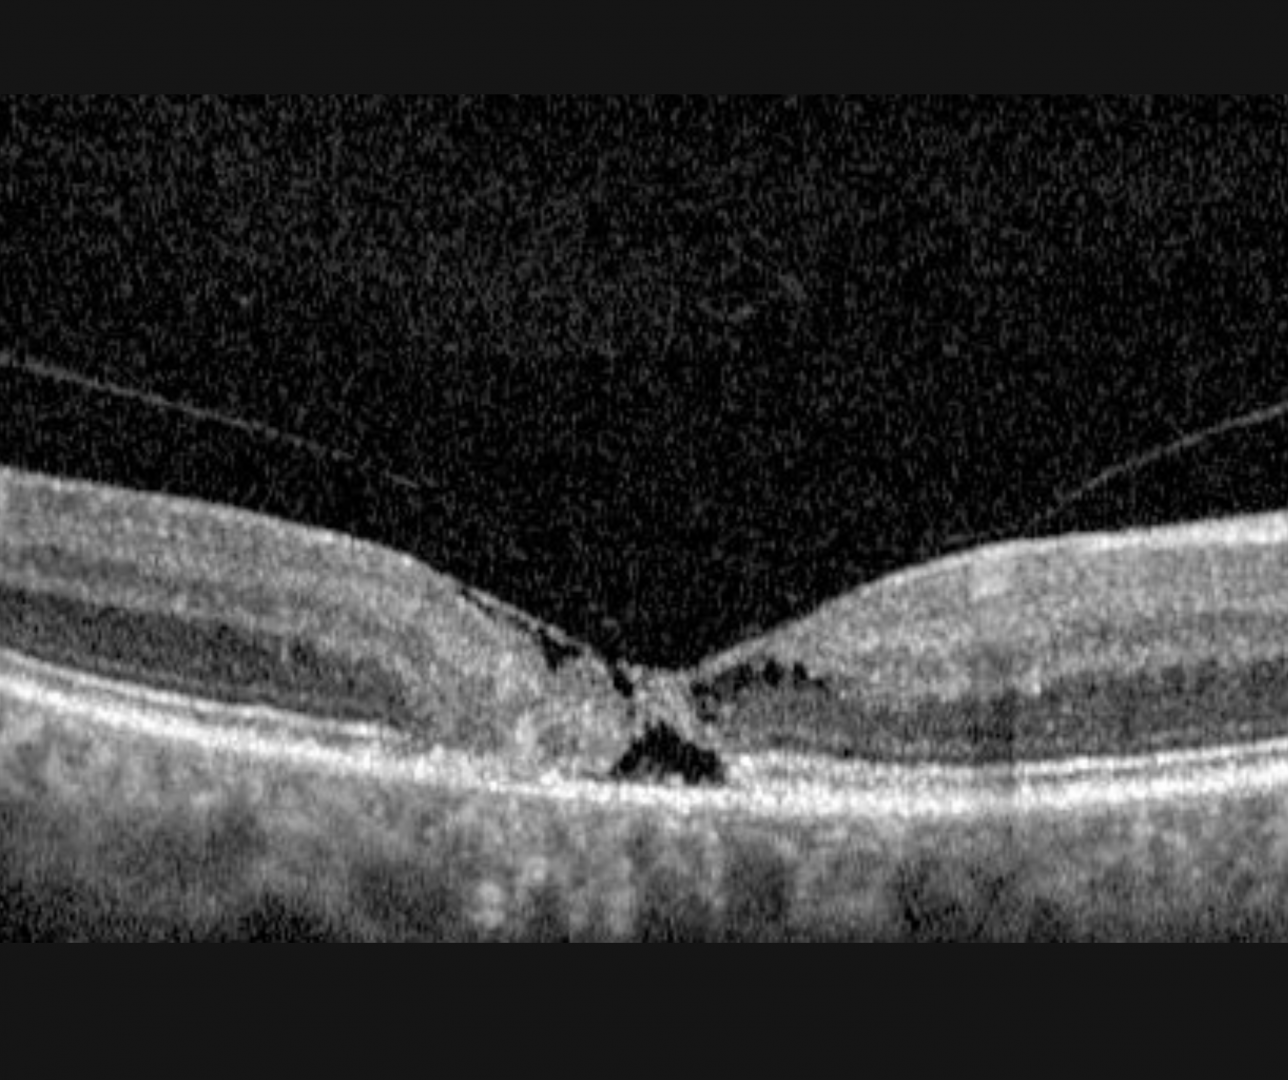

Overview
Mactel Type 2 is thought to be due to a neurodegenerative process with depletion of the Muller cells. It is a bilateral perifoveal vasculopathy of unknown cause, however a genetic component to this disease is highly likely. Symptoms typically start in the 5th or 6th decade of life and the early signs may be very subtle.
Signs and symptoms are typically limited to mildly reduced visual acuity and metamorphopsia, both of which are subtle at first but increase as the disease progresses. Typical clinical findings include a dulling or loss of the foveal reflex, a greying of the parafoveolar area, small foveal cystoid changes and pigment clumping. A pseudo-vitelliform lesion can also form in the central macula
There are two stages of disease: non proliferative and proliferative. In the proliferative stage, subretinal neovascularisation occurs with accompanying hard exudates, macula oedema and retinal haemorrhages.
Key funduscopic features include bilateral perifoveal/ juxafoveal capillary telangiectasia with a light grey discolouration, most often temporally. Superficial crystalline deposits and RPE hyperplasia may also be seen.
OCT features include foveal thinning, loss of the outer nuclear layer and ellipsoid zone that can progress to cystic spaces (termed ‘cavitations’) that involves all retinal layers. Often, the internal limiting membrane is spared, called ‘ILM drape’.
FAF can show an increased fluorescence in the temporal perifoveal region due to depletion in the macula pigment. In later stages, hypoautofluorescence can be seen due to RPE atrophy.
OCT angiography can reveal alterations in both the superficial and deep capillary plexus including loss of capillaries, dilation and telangiectasias. It may also identify new vessels in the proliferative stage.
Case Examples
-
Case 1
A 65 year old Caucasian male with best corrected visual acuities of 6/7.6+ (20/25+) in the right eye and 6/7.6+ (20/25+) in the left. He has noticed a central "spot" in h/is vision for approximately 5 years. Amsler grid revealed a distortion of the lines 4-5 degrees nasal from fixation in the right eye and a smaller area of distortion 3 degrees nasal to fixation in the left eye.
-
Case 2
A 72 year old female with best corrected vision of 6/9.5 (20/32) in the right eye and 6/6- (20/20-) in the left. She has noticed distortion in the vision of her right eye for approximately 7 years although testing with an Amsler grid was unremarkable.
-
Case 3
A 69 year old Caucasian female with best corrected visual acuity of 6/9.5 (20/32-) in the right eye.
Differential Diagnosis
References
Peter Charbel Issa, Mark C. Gillies, Emily Y. Chew, Alan C. Bird, Tjebo F.C. Heeren, Tunde Peto, Frank G. Holz, Hendrik P.N. Scholl, (2013) Macular telangiectasia type 2, Progress in Retinal and Eye Research, Volume 34, pages 49-77,


